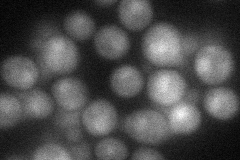
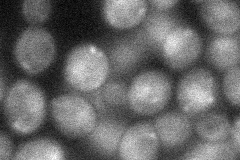
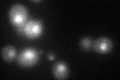

View description
RNA binding protein, component of the U1 snRNP protein; mutants are defective in meiotic recombination and in formation of viable spores, involved in the formation of DSBs through meiosis-specific splicing of MER2 pre-mRNA
Localization:
Intensity:
Fold change:
Significance:
-
C’ GFP library in SD

nucleus30.93 -
N' NOP1pr-GFP in SD

cytosol,nucleus59.6161 -
N' TEF2pr-mCherry in SD
nucleus34.3243 -
N' NATIVEpr-GFP in SD

nucleus24.1319 -
N' TEF2pr-VC and Cyto-VN in SD
cytosol30.6242 -
C’ GFP library in SD+DTT
nucleus38.871.25No -
C’ GFP library in SD+H2O2

nucleus28.570.92No -
C’ GFP library in Starvation Media

nucleus20.910.67Yes -
C’ GFP library on the background of Pup2-DaMP

N/A -
C’ GFP library on the background of CCT mutant

N/A0N/AYes
